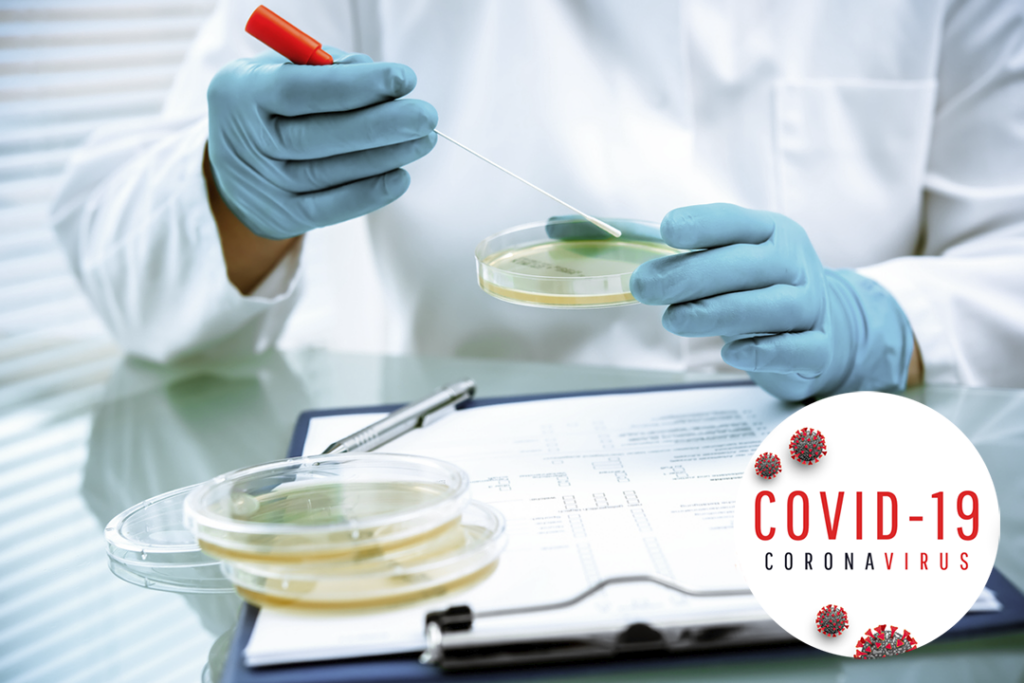

New Test Completed. Anolyt-pH Kills Viruses, Including the Coronavirus Family!

Now Our Disinfection Meets Yet Another EN Standard! Throughout the year, we have conducted several tests on our disinfection. Anolytech’s disinfection, Anolyt-pH, meets the requirements of six European standards for […]
Nytt prov avklarat. Anolyt-pH avdödar virus, även coronavirusfamiljen!
Nu uppfyller vår desinficering ytterliggare en EN-Standard! Vi har under året genomfört flera tester av vår desinficering. Anolytechs desinficering Anolyt-pH uppfyller kraven för 6 stycken europeiska standarder gällande desinficering inom […]